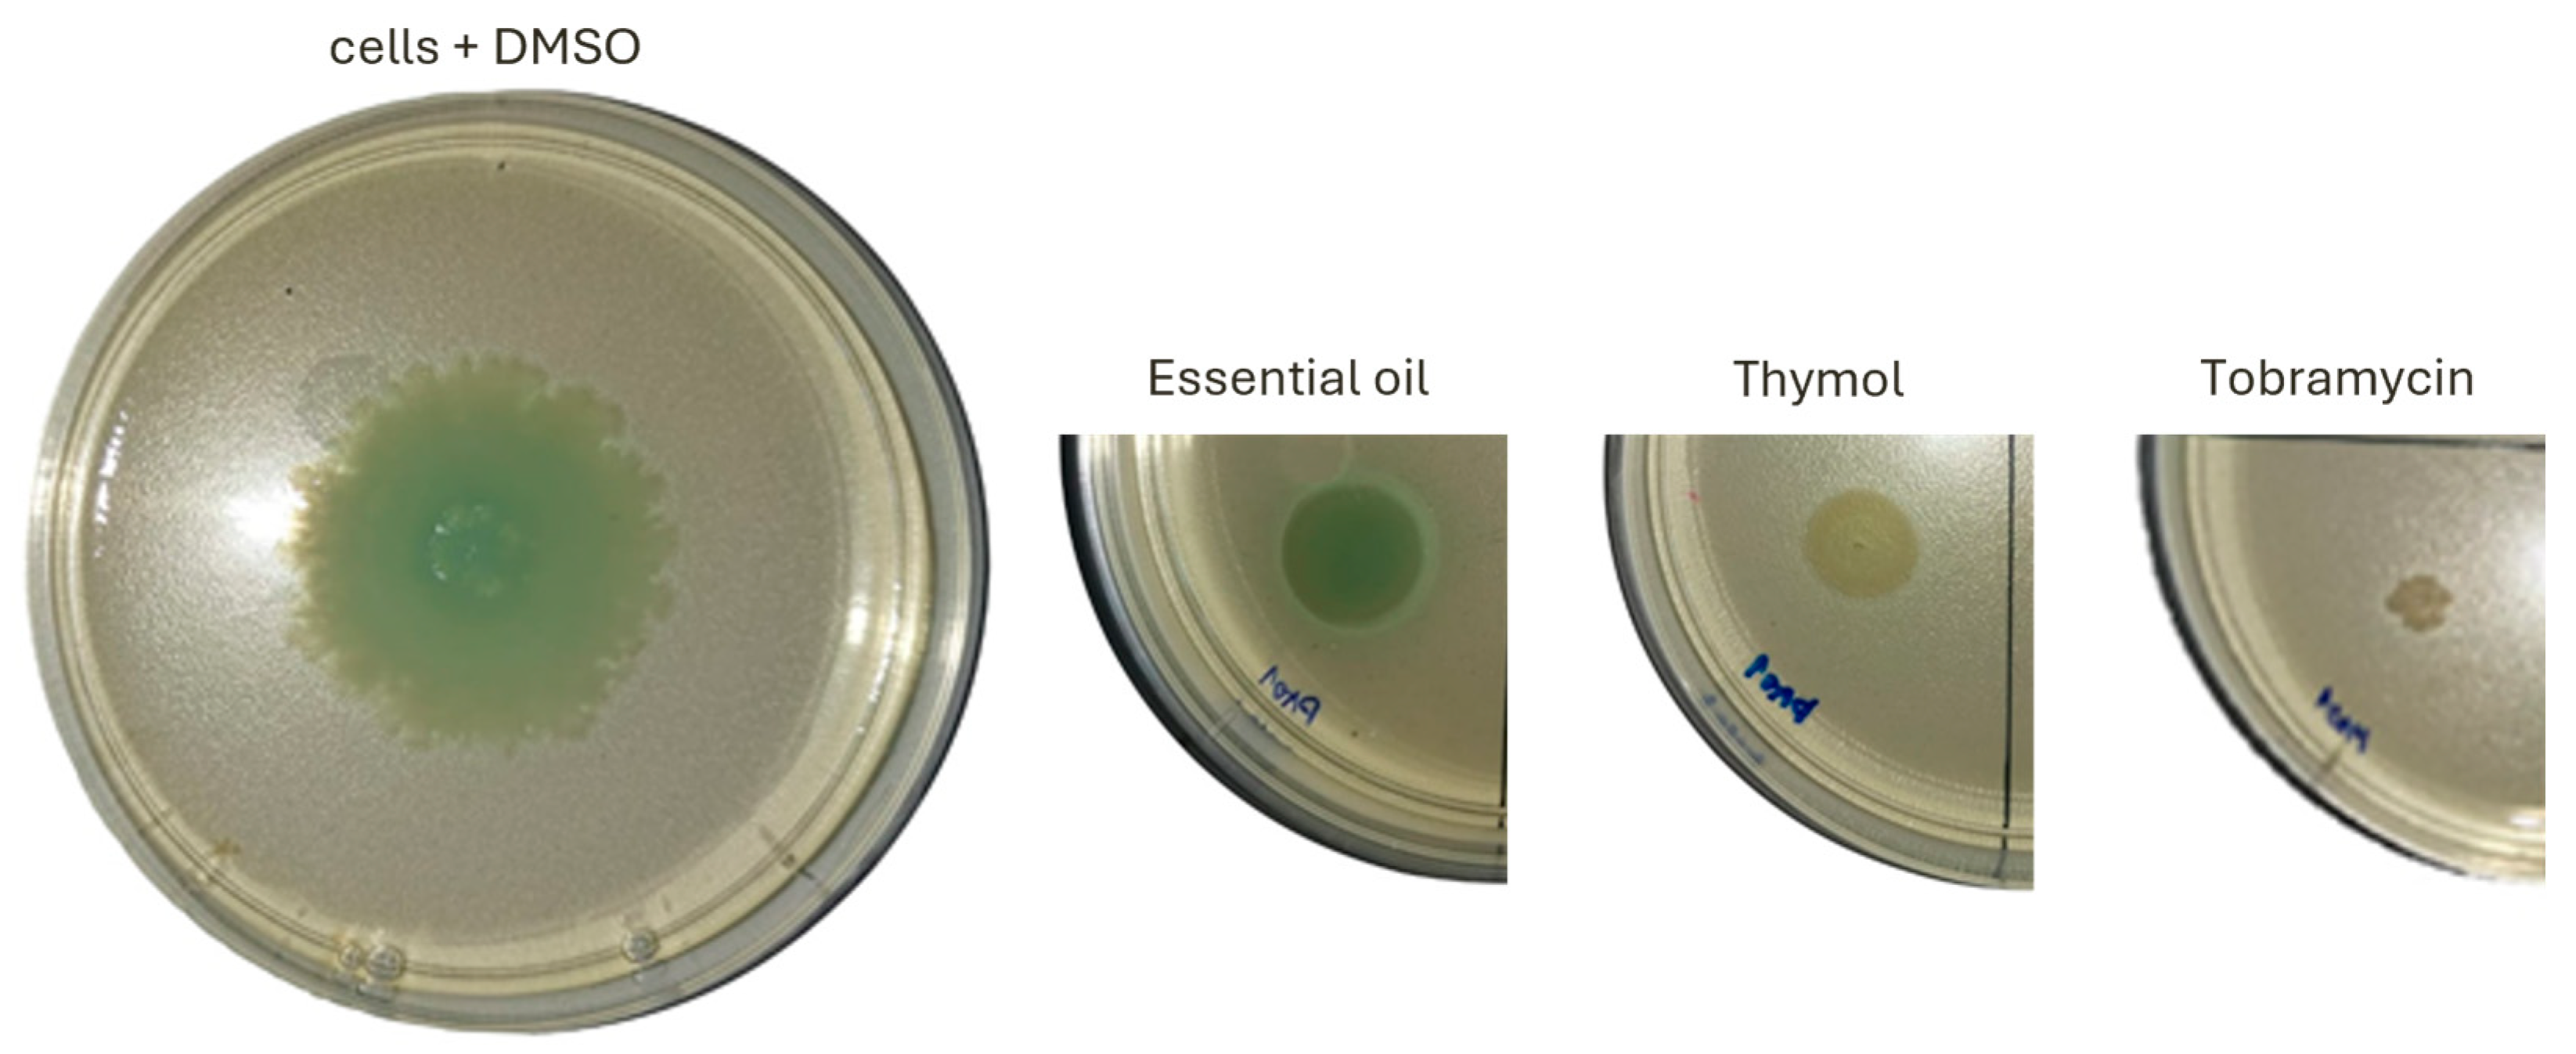
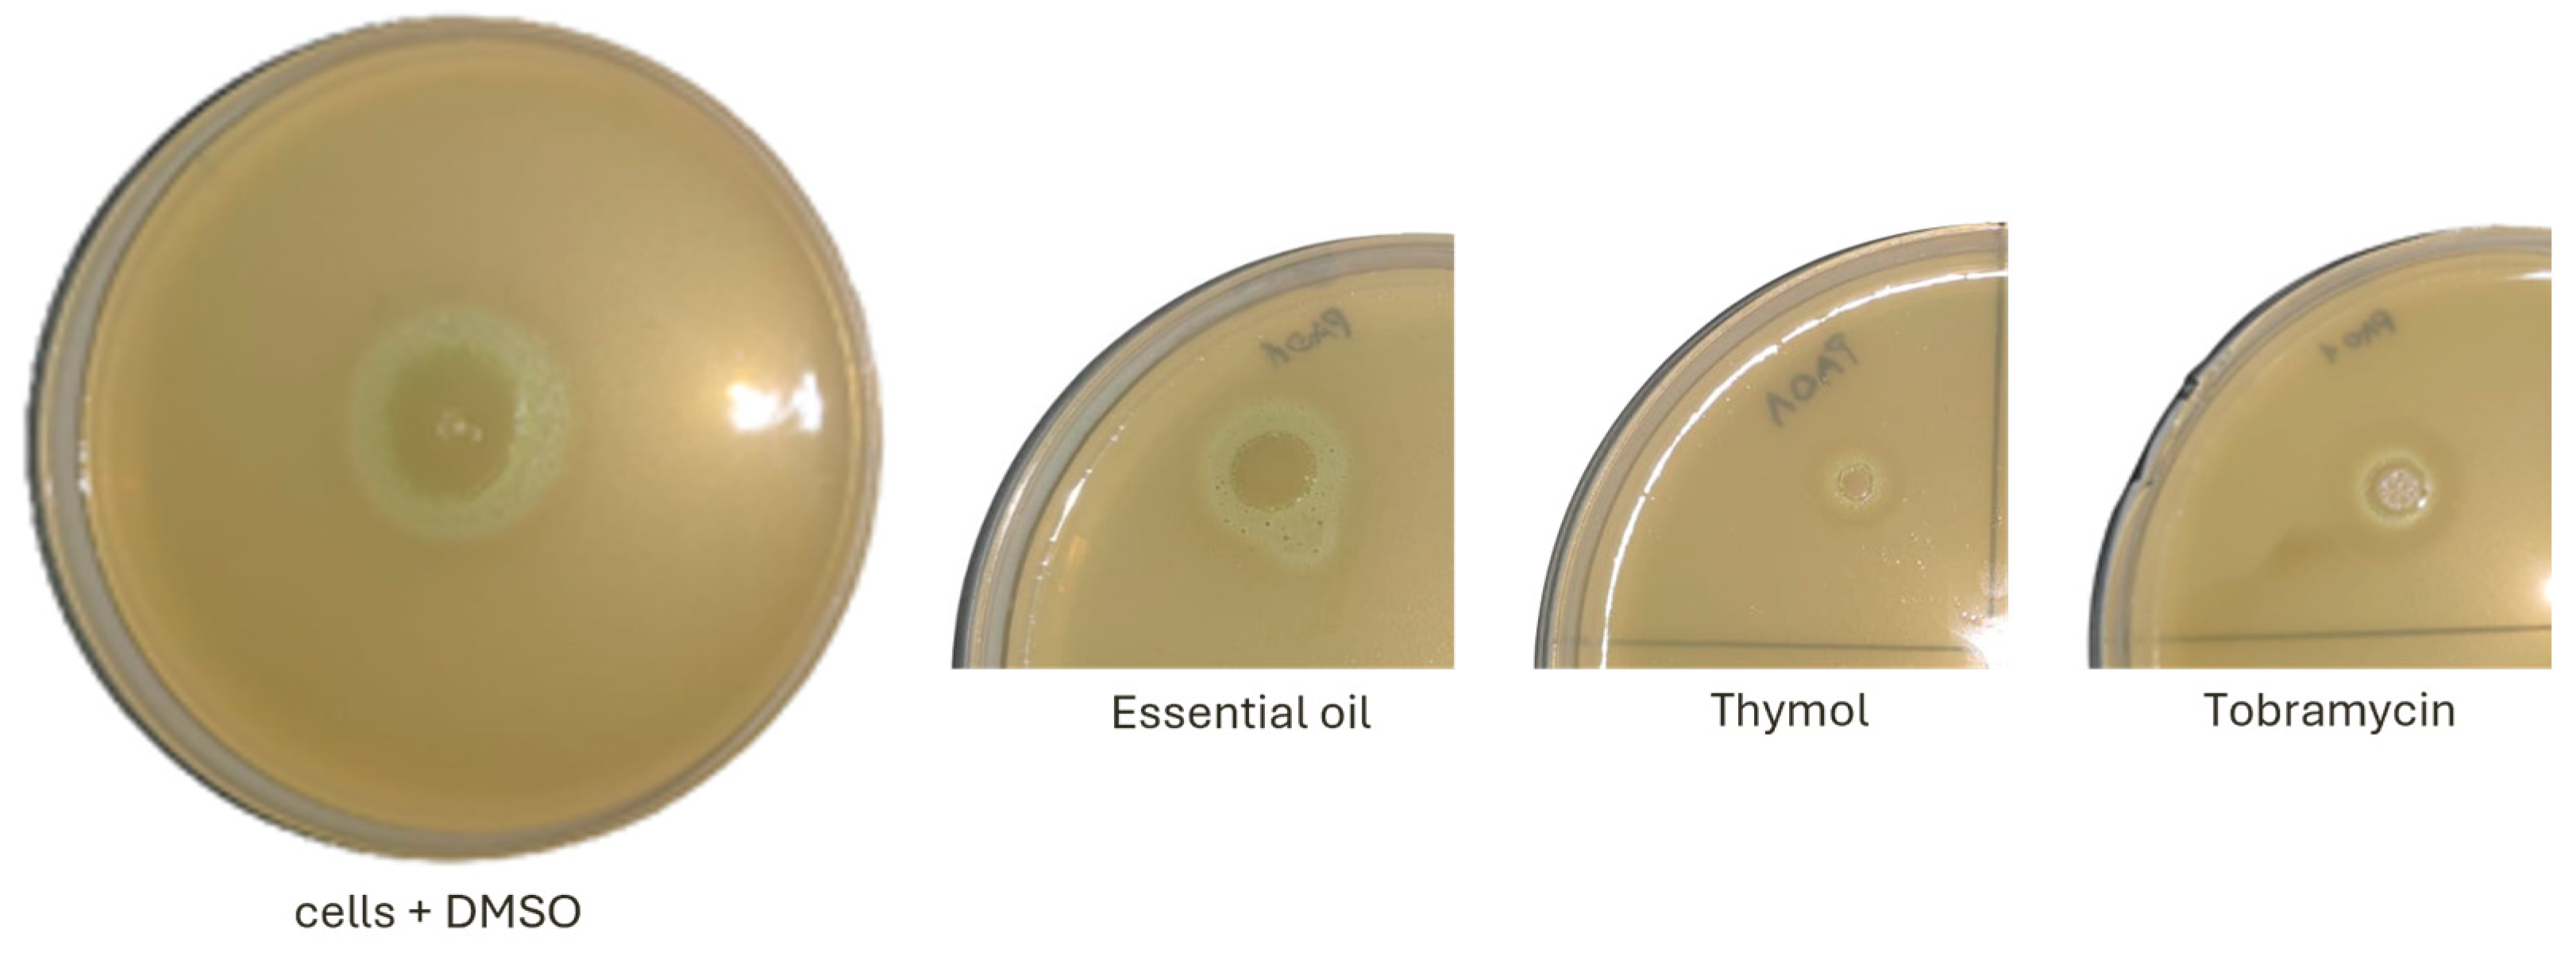

Modulatory Effects of Satureja montana L. Essential Oil on Biofilm Formation and Virulence Factors of Pseudomonas aeruginosa
Abstract
1. Introduction
2. Results
2.1. Content and Composition of Essential Oil from Winter Savory
2.2. Effect on the Planktonic Growth and Biofilm Formation
2.3. Effect on Motility and Virulence Factors
3. Discussion
4. Materials and Methods
4.1. Plant Material
4.2. Isolation of Essential Oil
4.3. Analysis of Essential Oil by Gas Chromatography-Mass Spectrometry (GC-MS)
4.4. Determination of Minimum Inhibitory Concentration (MIC)
4.5. Anti-Biofilm Assay
4.6. Swarming Motility Assay
4.7. Proteolytic Activity Assay
4.8. Pyocyanin Production Assay
4.9. Statistical Analysis
5. Conclusions
5.1. Key Findings
5.2. Implications and Future Directions
Author Contributions
Funding
Institutional Review Board Statement
Informed Consent Statement
Data Availability Statement
Acknowledgments
Conflicts of Interest
References
- WHO. 2021 Antibacterial Agents in Clinical and Preclinical Development; World Health Organization: Geneva, Switzerland, 2022; ISBN 978-92-4-004765-5.
- Salam, M.A.; Al-Amin, M.Y.; Salam, M.T.; Pawar, J.S.; Akhter, N.; Rabaan, A.A.; Alqumber, M.A.A. Antimicrobial Resistance: A Growing Serious Threat for Global Public Health. Healthcare 2023, 11, 1946. [Google Scholar] [CrossRef] [PubMed]
- Naghavi, M.; Vollset, S.E.; Ikuta, K.S.; Swetschinski, L.R.; Gray, A.P.; Wool, E.E.; Aguilar, G.R.; Mestrovic, T.; Smith, G.; Han, C.; et al. Global Burden of Bacterial Atimicrobial Resistance 1990–2021: A Systematic Analysis with Forecasts to 2050. Lancet 2024, 404, 1199–1226. [Google Scholar] [CrossRef]
- Javed, M.U.; Ijaz, M.; Ahmed, A.; Rasheed, H.; Sabir, M.; Jabir, A. Molecular Dynamics and Antimicrobial Resistance Pattern of β-lactam Resistant Coagulase Positive Staphylococcus aureus Isolated from Goat Mastitis. PVJ 2024, 44, 423–429. [Google Scholar] [CrossRef]
- Salikin, N.H.; Keong, L.C.; Azemin, W.-A.; Philip, N.; Yusuf, N.; Daud, S.A.; Rashid, S.A. Combating Multidrug-Resistant (MDR) Staphylococcus aureus Infection Using Terpene and Its Derivative. World J. Microbiol. Biotechnol. 2024, 40, 402. [Google Scholar] [CrossRef]
- Aljohani, A.S.M. Botanical Compounds: A Promising Approach to Control Mycobacterium Species of Veterinary and Zoonotic Importance. PVJ 2023, 43, 633–642. [Google Scholar] [CrossRef]
- Ibrahim, E.; Abdalhamed, A.; Arafa, A.; Eid, R.; Halil, H.M.; Hedia, R.; Dorgham, S.; Hozyen, H. In vitro and in vivo Antibacterial and Antibiofilm Efficacy of Selenium Nanoparticles against Staphylococcus aureus Supported with Toxicopathological and Behavioral Studies in Rats. Int. J. Vet. Sci. 2023, 13, 490–500. [Google Scholar] [CrossRef]
- Neagu, R.; Popovici, V.; Ionescu, L.E.; Ordeanu, V.; Popescu, D.M.; Ozon, E.A.; Gîrd, C.E. Antibacterial and Antibiofilm Effects of Different Samples of Five Commercially Available Essential Oils. Antibiotics 2023, 12, 1191. [Google Scholar] [CrossRef]
- Chouhan, S.; Sharma, K.; Guleria, S. Antimicrobial Activity of Some Essential Oils—Present Status and Future Perspectives. Medicines 2017, 4, 58. [Google Scholar] [CrossRef]
- Bakkali, F.; Averbeck, S.; Averbeck, D.; Idaomar, M. Biological Effects of Essential Oils—A Review. Food Chem. Toxicol. 2008, 46, 446–475. [Google Scholar] [CrossRef] [PubMed]
- Reichling, J. Anti-biofilm and Virulence Factor-Reducing Activities of Essential Oils and Oil Components as a Possible Option for Bacterial Infection Control. Planta Med. 2020, 86, 520–537. [Google Scholar] [CrossRef] [PubMed]
- Trifan, A.; Luca, S.V.; Greige-Gerges, H.; Miron, A.; Gille, E.; Aprotosoaie, A.C. Recent Advances in Tackling Microbial Multidrug Resistance with Essential Oils: Combinatorial and Nano-Based Strategies. Crit. Rev. Microbiol. 2020, 46, 338–357. [Google Scholar] [CrossRef]
- Khwaza, V.; Aderibigbe, B.A. Antibacterial Activity of Selected Essential Oil Components and Their Derivatives: A Review. Antibiotics 2025, 14, 68. [Google Scholar] [CrossRef]
- Les, F.; Galiffa, V.; Cásedas, G.; Moliner, C.; Maggi, F.; López, V.; Gómez-Rincón, C. Essential Oils of Two Subspecies of Satureja montana L. against Gastrointestinal Parasite Anisakis simplex and Acetylcholinesterase Inhibition. Molecules 2024, 29, 4640. [Google Scholar] [CrossRef]
- Maccelli, A.; Vitanza, L.; Imbriano, A.; Fraschetti, C.; Filippi, A.; Goldoni, P.; Maurizi, L.; Ammendolia, M.G.; Crestoni, M.E.; Fornarini, S.; et al. Satureja montana L. Essential Oils: Chemical Profiles/Phytochemical Screening, Antimicrobial Activity and O/W NanoEmulsion Formulations. Pharmaceutics 2019, 12, 7. [Google Scholar] [CrossRef] [PubMed]
- Said-Al Ahl, H.A.H.; Kačániova, M.; Mahmoud, A.A.; Hikal, W.M.; Čmiková, N.; Szczepanek, M.; Błaszczyk, K.; Al-Balawi, S.M.; Bianchi, A.; Smaoui, S.; et al. Phytochemical Characterization and Biological Activities of Essential Oil from Satureja montana L., a Medicinal Plant Grown under the Influence of Fertilization and Planting Dates. Biology 2024, 13, 328. [Google Scholar] [CrossRef] [PubMed]
- Hajdari, A.; Mustafa, B.; Kaçiku, A.; Mala, X.; Lukas, B.; Ibraliu, A.; Stefkov, G.; Novak, J. Chemical Composition of the Essential Oil, Total Phenolics, Total Flavonoids and Antioxidant Activity of Methanolic Extracts of Satureja montana L. Rec. Nat. Prod. 2016, 10, 750–760. [Google Scholar]
- Dodoš, T.; Janković, S.; Marin, P.D.; Rajčević, N. Essential Oil Composition and Micromorphological Traits of Satureja montana L., S. subspicata Bartel ex Vis., and S. kitaibelii Wierzb. Ex Heuff. Plant Organs. Plants 2021, 10, 511. [Google Scholar] [CrossRef]
- Capdevila, S.; Grau, D.; Cristóbal, R.; Moré, E.; De Las Heras, X. Chemical Composition of Wild Populations of Thymus vulgaris and Satureja montana in Central Catalonia, Spain. JSFA Rep. 2025, 5, 234–246. [Google Scholar] [CrossRef]
- Vitanza, L.; Maccelli, A.; Marazzato, M.; Scazzocchio, F.; Comanducci, A.; Fornarini, S.; Crestoni, M.E.; Filippi, A.; Fraschetti, C.; Rinaldi, F.; et al. Satureja montana L. Essential Oil and Its Antimicrobial Activity Alone or in Combination with Gentamicin. Microb. Pathog. 2019, 126, 323–331. [Google Scholar] [CrossRef]
- Aćimović, M.; Stanković Jeremić, J.; Todosijević, M.; Cvetković, M.; Lončar, B.; Vukić, V.; Erceg, T.; Pezo, L.; Zheljazkov, V.D. The Influence of Weather Conditions on the Immortelle Volatile Constituents from Essential oil and Hydrosol with a Focus on Italidiones and Its Molecular Docking Anti-Inflammatory Potential. Nat. Product. Commun. 2024, 19, 1934578X241284735. [Google Scholar] [CrossRef]
- Rezende, D.A.d.C.S.; Oliveira, C.D.; Batista, L.R.; Ferreira, V.R.F.; Brandão, R.M.; Caetano, A.R.S.; Alves, M.V.P.; Cardoso, M.G. Bactericidal and Antioxidant Effects of Essential Oils from Satureja montana L., Myristica fragrans H., and Cymbopogon flexuosus. Lett. Appl. Microbiol. 2022, 74, 741–751. [Google Scholar] [CrossRef] [PubMed]
- Ebani, V.V.; Bertelloni, F.; Najar, B.; Nardoni, S.; Pistelli, L.; Mancianti, F. Antimicrobial Activity of Essential Oils against Staphylococcus and Malassezia Strains Isolated from Canine Dermatitis. Microorganisms 2020, 8, 252. [Google Scholar] [CrossRef] [PubMed]
- Cagnoli, G.; Bertelloni, F.; Ebani, V.V. In Vitro Antibacterial Activity of Essential Oils from Origanum vulgare, Satureja montana, Thymus vulgaris, and Their Blend Against Necrotoxigenic (NTEC), Enteropathogenic (EPEC), and Shiga-Toxin Producing Escherichia coli (STEC) Isolates. Pathogens 2024, 13, 1077. [Google Scholar] [CrossRef]
- Šojić, B.; Ikonić, P.; Kocić-Tanackov, S.; Peulić, T.; Teslić, N.; Županjac, M.; Lončarević, I.; Zeković, Z.; Popović, M.; Vidaković, S.; et al. Antibacterial Activity of Selected Essential Oils against Foodborne Pathogens and Their Application in Fresh Turkey Sausages. Antibiotics 2023, 12, 182. [Google Scholar] [CrossRef] [PubMed]
- Rinaldi, F.; Maurizi, L.; Conte, A.L.; Marazzato, M.; Maccelli, A.; Crestoni, M.E.; Hanieh, P.N.; Forte, J.; Conte, M.P.; Zagaglia, C.; et al. Nanoemulsions of Satureja montana Essential Oil: Antimicrobial and Antibiofilm Activity against Avian Escherichia coli Strains. Pharmaceutics 2021, 13, 134. [Google Scholar] [CrossRef]
- Miladi, H.; Mili, D.; Ben Slama, R.; Zouari, S.; Ammar, E.; Bakhrouf, A. Antibiofilm Formation and Anti-Adhesive Property of Three Mediterranean Essential Oils Against a Foodborne Pathogen Salmonella Strain. Microbial. Pathogenesis 2016, 93, 22–31. [Google Scholar] [CrossRef]
- Ben Lagha, A.; Vaillancourt, K.; Maquera Huacho, P.; Grenier, D. Effects of Labrador Tea, Peppermint, and Winter Savory Essential Oils on Fusobacterium nucleatum. Antibiotics 2020, 9, 794. [Google Scholar] [CrossRef]
- Ramos, J.-L. (Ed.) Pseudomonas: Volume 1 Genomics, Life Style and Molecular Architecture; Springer: Boston, MA, USA, 2004; ISBN 978-1-4613-4788-0. [Google Scholar]
- Qin, S.; Xiao, W.; Zhou, C.; Pu, Q.; Deng, X.; Lan, L.; Liang, H.; Song, X.; Wu, M. Pseudomonas aeruginosa: Pathogenesis, Virulence Factors, Antibiotic Resistance, Interaction with Host, Technology Advances and Emerging Therapeutics. Signal Transduct. Target. Ther. 2022, 7, 199. [Google Scholar] [CrossRef] [PubMed]
- Eklöf, J.; Sørensen, R.; Ingebrigtsen, T.S.; Sivapalan, P.; Achir, I.; Boel, J.B.; Bangsborg, J.; Ostergaard, C.; Dessau, R.B.; Jensen, U.S.; et al. Pseudomonas aeruginosa and Risk of Death and Exacerbations in Patients with Chronic Obstructive Pulmonary Disease: An Observational Cohort Study of 22,053 Patients. Clin. Microbiol. Infect. 2020, 26, 227–234. [Google Scholar] [CrossRef]
- Recanatini, C.; Van Werkhoven, C.H.; Van Der Schalk, T.E.; Paling, F.; Hazard, D.; Timbermont, L.; Torrens, G.; DiGiandomenico, A.; Esser, M.T.; Wolkewitz, M.; et al. Impact of Pseudomonas aeruginosa Carriage on Intensive Care Unit-Acquired Pneumonia: A European Multicentre Prospective Cohort Study. Clin. Microbiol. Infect. 2025, 31, 433–440. [Google Scholar] [CrossRef] [PubMed]
- Sanjar, F.; Millan, C.P.; Leung, K.P. Phylogenetic Evaluation and Genotypic Identification of Burn-Related Pseudomonas aeruginosa Strains Isolated from Post-Burn Human Infections During Hospitalization. Pathog. Dis. 2024, 82, ftae021. [Google Scholar] [CrossRef] [PubMed]
- Harris, A.D.; Jackson, S.S.; Robinson, G.; Pineles, L.; Leekha, S.; Thom, K.A.; Wang, Y.; Doll, M.; Pettigrew, M.M.; Johnson, J.K. Pseudomonas aeruginosa Colonization in the Intensive Care Unit: Prevalence, Risk Factors, and Clinical Outcomes. Infect. Control Hosp. Epidemiol. 2016, 37, 544–548. [Google Scholar] [CrossRef]
- Malhotra, S.; Hayes, D.; Wozniak, D.J. Cystic Fibrosis and Pseudomonas aeruginosa: The Host-Microbe Interface. Clin. Microbiol. Rev. 2019, 32, e00138-18. [Google Scholar] [CrossRef]
- Fernández-Billón, M.; Llambías-Cabot, A.E.; Jordana-Lluch, E.; Oliver, A.; Macià, M.D. Mechanisms of Antibiotic Resistance in Pseudomonas aeruginosa Biofilms. Biofilm 2023, 5, 100129. [Google Scholar] [CrossRef] [PubMed]
- Lee, J.; Zhang, L. The Hierarchy Quorum Sensing Network in Pseudomonas aeruginosa. Protein Cell 2015, 6, 26–41. [Google Scholar] [CrossRef]
- Vestby, L.K.; Grønseth, T.; Simm, R.; Nesse, L.L. Bacterial Biofilm and its Role in the Pathogenesis of Disease. Antibiotics 2020, 9, 59. [Google Scholar] [CrossRef]
- Jurado-Martín, I.; Sainz-Mejías, M.; McClean, S. Pseudomonas aeruginosa: An Audacious Pathogen with an Adaptable Arsenal of Virulence Factors. Int. J. Mol. Sci. 2021, 22, 3128. [Google Scholar] [CrossRef] [PubMed]
- Stojanović-Radić, Z.; Pejčić, M.; Stojanović, N.; Sharifi-Rad, J.; Stanković, N. Potential of Ocimum basilicum L. and Salvia officinalis L. Essential Oils Against Biofilms of P. aeruginosa Clinical Isolates. Cell Mol. Biol. 2016, 62, 27–33. [Google Scholar] [CrossRef]
- Pejčić, M.; Stojanović-Radić, Z.; Genčić, M.; Dimitrijević, M.; Radulović, N. Anti-Virulence Potential of Basil and Sage Essential Oils: Inhibition of Biofilm Formation, Motility and Pyocyanin Production of Pseudomonas aeruginosa Isolates. Food Chem. Toxicol. 2020, 141, 111431. [Google Scholar] [CrossRef]
- Haripriyan, J.; Binu, C.R.; Menon, N.D.; Vanuopadath, M.; Hari, M.B.; Namitha, N.; Binoy, K.; Kumar, A.; Nair, B.G.; Nizet, V.; et al. Essential Oils Modulate Virulence Phenotypes in a Multidrug-Resistant Pyomelanogenic Pseudomonas aeruginosa Clinical Isolate. Sci. Rep. 2025, 15, 3738. [Google Scholar] [CrossRef]
- Coșeriu, R.L.; Vintilă, C.; Pribac, M.; Mare, A.D.; Ciurea, C.N.; Togănel, R.O.; Cighir, A.; Simion, A.; Man, A. Antibacterial Effect of 16 Essential Oils and Modulation of mex Efflux Pumps Gene Expression on Multidrug-Resistant Pseudomonas aeruginosa Clinical Isolates: Is Cinnamon a Good Fighter? Antibiotics 2023, 12, 163. [Google Scholar] [CrossRef] [PubMed]
- Van, L.T.; Hagiu, I.; Popovici, A.; Marinescu, F.; Gheorghe, I.; Curutiu, C.; Ditu, L.M.; Holban, A.-M.; Sesan, T.E.; Lazar, V. Antimicrobial Efficiency of Some Essential Oils in Antibiotic-Resistant Pseudomonas aeruginosa Isolates. Plants 2022, 11, 2003. [Google Scholar] [CrossRef] [PubMed]
- Skočibušić, M.; Bezić, N. Chemical Composition and Antimicrobial Variability of Satureja montana L. Essential Oils Produced During Ontogenesis. J. Essent. Oil Res. 2004, 16, 387–391. [Google Scholar] [CrossRef]
- Čabarkapa, I.; Čolović, R.; Đuragić, O.; Popović, S.; Kokić, B.; Milanov, D.; Pezo, L. Anti-Biofilm Activities of Essential Oils Rich in Carvacrol and Thymol Against Salmonella enteritidis. Biofouling 2019, 35, 361–375. [Google Scholar] [CrossRef]
- Kollaran, A.M.; Joge, S.; Kotian, H.S.; Badal, D.; Prakash, D.; Mishra, A.; Varma, M.; Singh, V. Context-Specific Requirement of Forty-Four Two-Component Loci in Pseudomonas aeruginosa Swarming. iScience 2019, 13, 305–317. [Google Scholar] [CrossRef]
- Bezbradica, D.I.; Tomovic, J.M.; Vukasinovic, M.S.; Siler-Marinkovic, S.; Ristic, M.M. Composition and Antimicrobial Activity of Essential Oil of Satureja montana L. Collected in Serbia and Montenegro. J. Essent. Oil Res. 2005, 17, 462–465. [Google Scholar] [CrossRef]
- Ćavar, S.; Maksimović, M.; Šolić, M.E.; Jerković-Mujkić, A.; Bešta, R. Chemical Composition and Antioxidant and Antimicrobial Activity of Two Satureja Essential Oils. Food Chem. 2008, 111, 648–653. [Google Scholar] [CrossRef]
- Djordjevic, N.; Mancic, S.; Karabegovic, I.; Cvetkovic, D.; Stanojevic, J.; Savic, D.; Danilovic, B. Influence of the Isolation Method to the Composition and Antimicrobial and Antioxidative Activity of Winter Savory (Satureja montana L.) Essential Oil. J. Essent. Oil Bear. Plants 2021, 24, 386–399. [Google Scholar] [CrossRef]
- Walczak, M.; Michalska-Sionkowska, M.; Olkiewicz, D.; Tarnawska, P.; Warżyńska, O. Potential of Carvacrol and Thymol in Reducing Biofilm Formation on Technical Surfaces. Molecules 2021, 26, 2723. [Google Scholar] [CrossRef] [PubMed]
- Mastelić, J.; Jerković, I. Gas Chromatography–Mass Spectrometry Analysis of Free and Glycoconjugated Aroma Compounds of Seasonally Collected Satureja montana L. Food Chemistry 2003, 80, 135–140. [Google Scholar] [CrossRef]
- Skočibušić, M.; Bezić, N. Phytochemical Analysis and In Vitro Antimicrobial Activity of Two Satureja Species Essential Oils. Phytother. Res. 2004, 18, 967–970. [Google Scholar] [CrossRef]
- Milos, M.; Radonic, A.; Bezic, N.; Dunkic, V. Localities and Seasonal Variations in the Chemical Composition of Essential Oils of Satureja montana L. and S. cuneifolia Ten. Flavour Fragr. J. 2001, 16, 157–160. [Google Scholar] [CrossRef]
- Radonic, A.; Milos, M. Chemical Composition and In Vitro Evaluation of Antioxidant Effect of Free Volatile Compounds from Satureja montana L. Free Radic. Res. 2003, 37, 673–679. [Google Scholar] [CrossRef]
- Stanic, G.; Petricic, J.; Blazevic, N. Gas Chromatographic Investigations of Essential Oils of Satureja montana and Satureja subspicata from Yugoslavia. J. Essent. Oil Res. 1991, 3, 153–158. [Google Scholar] [CrossRef]
- Ibraliu, A.; Dhillon, B.S.; Faslia, N.; Stich, B. Variability of Essential Oil Composition in Albanian Accessions of Satureja montana L. J. Med. Plants Res. 2010, 4, 1359–1364. [Google Scholar]
- Djenane, D.; Yangüela, J.; Montañés, L.; Djerbal, M.; Roncalés, P. Antimicrobial Activity of Pistacia lentiscus and Satureja montana Essential Oils Against Listeria monocytogenes CECT 935 Using Laboratory Media: Efficacy and Synergistic Potential in Minced Beef. Food Control 2011, 22, 1046–1053. [Google Scholar] [CrossRef]
- Serrano, C.; Matos, O.; Teixeira, B.; Ramos, C.; Neng, N.; Nogueira, J.; Nunes, M.L.; Marques, A. Antioxidant and Antimicrobial Activity of Satureja montana L. Extracts. J. Sci. Food Agric. 2011, 91, 1554–1560. [Google Scholar] [CrossRef]
- Tepe, B.; Cilkiz, M. A Pharmacological and Phytochemical Overview on Satureja. Pharm. Biol. 2016, 54, 375–412. [Google Scholar] [CrossRef]
- Abbad, I.; Soulaimani, B.; Iriti, M.; Barakate, M. Chemical Composition and Synergistic Antimicrobial Effects of Essential Oils From Four Commonly Used Satureja Species in Combination With Two Conventional Antibiotics. Chem. Biodivers. 2025, 22, e202402093. [Google Scholar] [CrossRef]
- Farhadi, K.; Rajabi, E.; Varpaei, H.A.; Iranzadasl, M.; Khodaparast, S.; Salehi, M. Thymol and Carvacrol Against Klebsiella: Anti-Bacterial, Anti-Biofilm, and Synergistic Activities—A Systematic Review. Front. Pharmacol. 2024, 15, 1487083. [Google Scholar] [CrossRef]
- Peter, S.; Sotondoshe, N.; Aderibigbe, B.A. Carvacrol and Thymol Hybrids: Potential Anticancer and Antibacterial Therapeutics. Molecules 2024, 29, 2277. [Google Scholar] [CrossRef] [PubMed]
- Marchese, A.; Orhan, I.E.; Daglia, M.; Barbieri, R.; Di Lorenzo, A.; Nabavi, S.F.; Gortzi, O.; Izadi, M.; Nabavi, S.M. Antibacterial and Antifungal Activities of Thymol: A Brief Review of the Literature. Food Chem. 2016, 210, 402–414. [Google Scholar] [CrossRef]
- Jo, E.-R.; Oh, J.; Cho, S.I. Inhibitory Effect of Thymol on Tympanostomy Tube Biofilms of Methicillin-Resistant Staphylococcus aureus and Ciprofloxacin-Resistant Pseudomonas aeruginosa. Microorganisms 2022, 10, 1867. [Google Scholar] [CrossRef]
- Ma, Z.; Qian, C.; Zhong, Z.; Yao, Z.; You, C.; Cao, J.; Zhou, C.; Ye, J. Thymol Combined with SAEW for the Eradication of Mature Pseudomonas aeruginosa Biofilms and Reduction of Bacterial Virulence. Front. Microbiol. 2025, 16, 1547632. [Google Scholar] [CrossRef]
- Niu, C.; Gilbert, E.S. Colorimetric Method for Identifying Plant Essential Oil Components That Affect Biofilm Formation and Structure. Appl. Environ. Microbiol. 2004, 70, 6951–6956. [Google Scholar] [CrossRef]
- Aquino, S.F.; Stuckey, D.C. Soluble Microbial Products Formation in Anaerobic Chemostats in the Presence of Toxic Compounds. Water Res. 2004, 38, 255–266. [Google Scholar] [CrossRef]
- Fang, H.H.P.; Xu, L.-C.; Chan, K.-Y. Effects of Toxic Metals and Chemicals on Biofilm and Biocorrosion. Water Res. 2002, 36, 4709–4716. [Google Scholar] [CrossRef]
- Burt, S. Essential Oils: Their Antibacterial Properties and Potential Applications in Foods—A Review. Int. J. Food Microbiol. 2004, 94, 223–253. [Google Scholar] [CrossRef] [PubMed]
- Liu, T.; Kang, J.; Liu, L. Thymol as a Critical Component of Thymus vulgaris L. Essential Oil Combats Pseudomonas aeruginosa by Intercalating DNA and Inactivating Biofilm. LWT 2021, 136, 110354. [Google Scholar] [CrossRef]
- Chatterjee, B.; Vittal, R.R. Quorum Sensing Modulatory and Biofilm Inhibitory Activity of Plectranthus barbatus Essential Oil: A Novel Intervention Strategy. Arch. Microbiol. 2021, 203, 1767–1778. [Google Scholar] [CrossRef]
- Merghni, A.; Haddaji, N.; Bouali, N.; Alabbosh, K.F.; Adnan, M.; Snoussi, M.; Noumi, E. Comparative Study of Antibacterial, Antibiofilm, Antiswarming and Antiquorum Sensing Activities of Origanum vulgare Essential Oil and Terpinene-4-ol against Pathogenic Bacteria. Life 2022, 12, 1616. [Google Scholar] [CrossRef]
- Vrenna, G.; Artini, M.; Ragno, R.; Relucenti, M.; Fiscarelli, E.V.; Tuccio Guarna Assanti, V.; Papa, R.; Selan, L. Anti-Virulence Properties of Coridothymus capitatus Essential Oil against Pseudomonas aeruginosa Clinical Isolates from Cystic Fibrosis Patients. Microorganisms 2021, 9, 2257. [Google Scholar] [CrossRef]
- Noumi, E.; Ahmad, I.; Adnan, M.; Patel, H.; Merghni, A.; Haddaji, N.; Bouali, N.; Alabbosh, K.F.; Kadri, A.; Caputo, L.; et al. Illicium verum L. (Star Anise) Essential Oil: GC/MS Profile, Molecular Docking Study, In Silico ADME Profiling, Quorum Sensing, and Biofilm-Inhibiting Effect on Foodborne Bacteria. Molecules 2023, 28, 7691. [Google Scholar] [CrossRef]
- Ghannay, S.; Aouadi, K.; Kadri, A.; Snoussi, M. GC-MS Profiling, Vibriocidal, Antioxidant, Antibiofilm, and Anti-Quorum Sensing Properties of Carum carvi L. Essential Oil: In Vitro and In Silico Approaches. Plants 2022, 11, 1072. [Google Scholar] [CrossRef]
- Fekry, M.; Yahya, G.; Osman, A.; Al-Rabia, M.W.; Mostafa, I.; Abbas, H.A. GC-MS Analysis and Microbiological Evaluation of Caraway Essential Oil as a Virulence Attenuating Agent against Pseudomonas aeruginosa. Molecules 2022, 27, 8532. [Google Scholar] [CrossRef] [PubMed]
- Khedhri, S.; Polito, F.; Caputo, L.; Manna, F.; Khammassi, M.; Hamrouni, L.; Amri, I.; Nazzaro, F.; De Feo, V.; Fratianni, F. Chemical Composition, Phytotoxic and Antibiofilm Activity of Seven Eucalyptus Species from Tunisia. Molecules 2022, 27, 8227. [Google Scholar] [CrossRef] [PubMed]
- European Pharmacopoeia Online. Available online: https://pheur.edqm.eu/subhome/11-8 (accessed on 19 September 2024).
- Adams, R.P. Identification of Essential Oil Components by Gas Chromatography/Mass Spectrometry; Allured Publishing Corporation: Carol Stream, IL, USA, 2007; ISBN 978-1-932633-21-4. [Google Scholar]
- Andrews, J.M. Determination of Minimum Inhibitory Concentrations. J. Antimicrob. Chemother. 2001, 48, 5–16. [Google Scholar] [CrossRef]
- O’Toole, G.A. Microtiter Dish Biofilm Formation Assay. JoVE 2011, 47, e2437. [Google Scholar] [CrossRef]
- Savoia, D.; Zucca, M. Clinical and Environmental Burkholderia Strains: Biofilm Production and Intracellular Survival. Curr. Microbiol. 2007, 54, 440–444. [Google Scholar] [CrossRef]
- Filloux, A.; Ramos, J.-L. (Eds.) Pseudomonas Methods and Protocols; Methods in Molecular Biology; Springer: New York, NY, USA, 2014; ISBN 978-1-4939-0472-3. [Google Scholar]
- Essar, D.W.; Eberly, L.; Hadero, A.; Crawford, I.P. Identification and Characterization of Genes for a Second Anthranilate Synthase in Pseudomonas aeruginosa: Interchangeability of the Two Anthranilate Synthases and Evolutionary Implications. J. Bacteriol. 1990, 172, 884–900. [Google Scholar] [CrossRef]

| No. a | RI b | Compound | Relative Percentage (%) |
|---|---|---|---|
| 1 | 925 | α-Thujene | 0.53 |
| 2 | 932 | α-Pinene | 0.34 |
| 3 | 947 | Camphene | 0.17 |
| 4 | 977 | 1-Octen-3-ol | 0.30 |
| 5 | 990 | Myrcene | 0.60 |
| 6 | 1005 | α-Phellandrene | 0.14 |
| 7 | 1016 | α-Terpinene | 1.43 |
| 8 | 1023 | p-Cymene | 7.24 |
| 9 | 1027 | Limonene | 0.31 |
| 10 | 1036 | cis-β-Ocimene | 0.29 |
| 11 | 1057 | γ-Terpinene | 5.77 |
| 12 | 1066 | cis-Sabinene hydrate | 0.12 |
| 13 | 1101 | Linalool | 0.17 |
| 14 | 1164 | Borneol | 0.83 |
| 15 | 1176 | Terpinen-4-ol | 0.66 |
| 16 | 1234 | Thymol methyl ether | 8.75 |
| 17 | 1239 | Pulegone | 0.22 |
| 18 | 1243 | Carvacrol methyl ether | 6.80 |
| 19 | 1294 | Thymol | 56.47 |
| 20 | 1303 | Carvacrol | 1.18 |
| 21 | 1354 | Thymol acetate | 0.22 |
| 22 | 1417 | β-Caryophyllene | 3.10 |
| 23 | 1474 | γ-Muurolene | 0.14 |
| 24 | 1492 | γ-Amorphene | 0.19 |
| 25 | 1507 | β-Bisabolene | 0.35 |
| 26 | 1511 | γ-Cadinene | 0.16 |
| 27 | 1522 | δ-Cadinene | 0.29 |
| 28 | 1574 | Spathulenol | 0.12 |
| 29 | 1580 | Caryophyllene oxide | 2.30 |
Disclaimer/Publisher’s Note: The statements, opinions and data contained in all publications are solely those of the individual author(s) and contributor(s) and not of MDPI and/or the editor(s). MDPI and/or the editor(s) disclaim responsibility for any injury to people or property resulting from any ideas, methods, instructions or products referred to in the content. |
© 2025 by the authors. Licensee MDPI, Basel, Switzerland. This article is an open access article distributed under the terms and conditions of the Creative Commons Attribution (CC BY) license (https://creativecommons.org/licenses/by/4.0/).
Share and Cite
Maravić-Vlahoviček, G.; Kindl, M.; Andričević, K.; Obranić, S.; Vladimir-Knežević, S. Modulatory Effects of Satureja montana L. Essential Oil on Biofilm Formation and Virulence Factors of Pseudomonas aeruginosa. Pharmaceuticals 2025, 18, 1269. https://doi.org/10.3390/ph18091269
Maravić-Vlahoviček G, Kindl M, Andričević K, Obranić S, Vladimir-Knežević S. Modulatory Effects of Satureja montana L. Essential Oil on Biofilm Formation and Virulence Factors of Pseudomonas aeruginosa. Pharmaceuticals. 2025; 18(9):1269. https://doi.org/10.3390/ph18091269
Chicago/Turabian StyleMaravić-Vlahoviček, Gordana, Marija Kindl, Klara Andričević, Sonja Obranić, and Sanda Vladimir-Knežević. 2025. "Modulatory Effects of Satureja montana L. Essential Oil on Biofilm Formation and Virulence Factors of Pseudomonas aeruginosa" Pharmaceuticals 18, no. 9: 1269. https://doi.org/10.3390/ph18091269
APA StyleMaravić-Vlahoviček, G., Kindl, M., Andričević, K., Obranić, S., & Vladimir-Knežević, S. (2025). Modulatory Effects of Satureja montana L. Essential Oil on Biofilm Formation and Virulence Factors of Pseudomonas aeruginosa. Pharmaceuticals, 18(9), 1269. https://doi.org/10.3390/ph18091269







